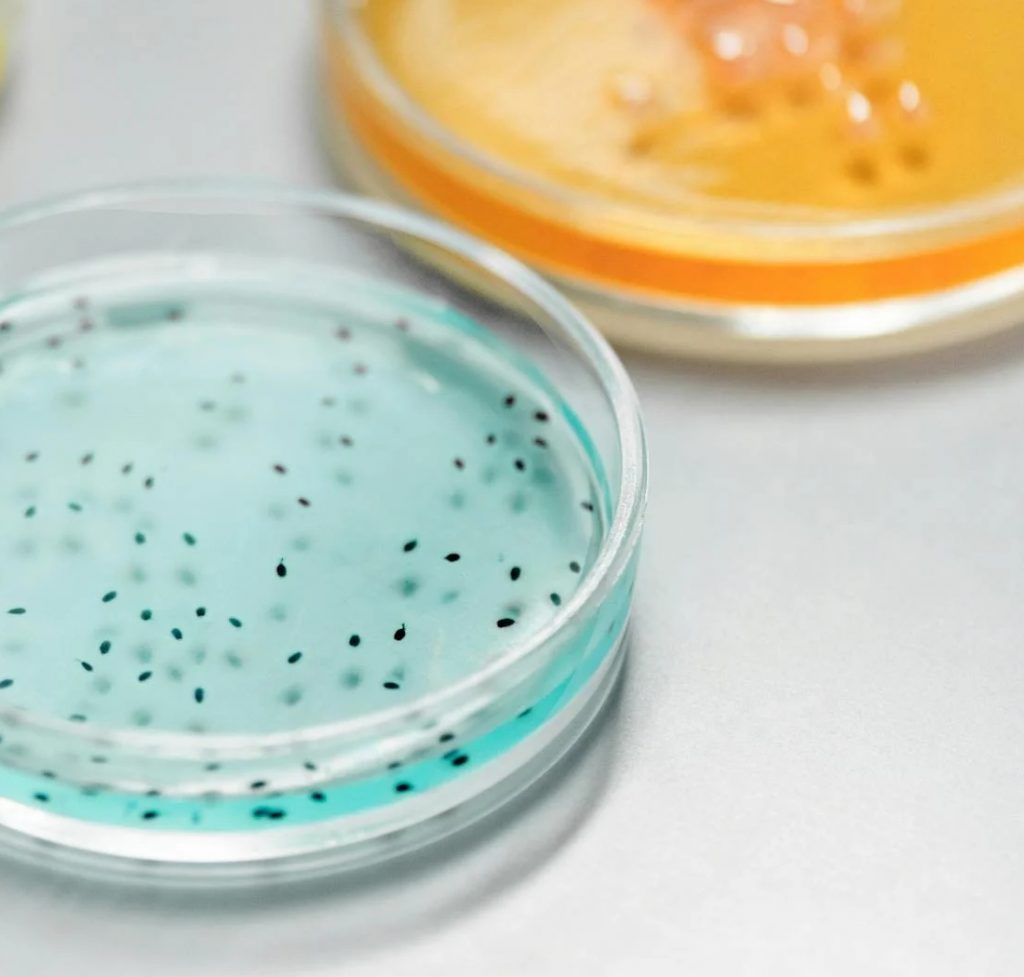

Enfrentando el Sesgo hacia la Experimentación Animal
A pesar del avance de métodos científicos sin animales, aún persiste un sesgo hacia el uso tradicional de animales en investigación biomédica, lo que limita la adopción de alternativas más éticas.
Existen leyes y políticas en todo el mundo que promueven la sustitución y reducción del uso de animales no humanos en la ciencia. Estos principios se basan no solo en consideraciones éticas para los animales, sino también en consideraciones científicas sobre las limitaciones del uso de animales no humanos para modelar la biología, la salud y las enfermedades humanas. Los nuevos enfoques de investigación sin animales que utilizan la biología, las células y los datos humanos para imitar estados fisiológicos humanos complejos y respuestas terapéuticas se han vuelto cada vez más eficaces y accesibles, reemplazando el uso de animales en diversas aplicaciones y convirtiéndose en una herramienta crucial para la investigación biomédica y el desarrollo de fármacos. A pesar de sus numerosas ventajas, la aceptación de estos nuevos métodos sin animales ha sido lenta y persisten barreras para su adopción generalizada. Una de estas barreras es el sesgo de los métodos animales, la preferencia por métodos basados en animales cuando no son necesarios o cuando los métodos sin animales son adecuados. Este sesgo puede afectar las evaluaciones de la investigación y disuadir a los investigadores de utilizar nuevos enfoques sin animales. Este artículo ofrece una visión general del sesgo de los métodos animales para el público general, revisando la evidencia, explorando las consecuencias y analizando las iniciativas de mitigación en curso destinadas a reducir las barreras que impiden el uso de animales en la investigación y las pruebas biomédicas.
Métodos de investigación preclínica con animales y humanos
Los experimentos con animales se realizan con frecuencia para la investigación básica (con el objetivo de obtener conocimientos sin aplicaciones específicas) y para la investigación aplicada (aplicación de conocimientos, por ejemplo, para intentar encontrar nuevos fármacos para humanos y evaluar su toxicidad o seguridad). Según la directiva sobre el uso de animales en la ciencia de la Unión Europea, los experimentos con animales deben sustituirse siempre que sea posible, y los Estados miembros de la UE deben realizar un esfuerzo sustancial para reducir y sustituir el uso de animales en la ciencia (Parlamento Europeo, 2010). Un principio similar se aplica en otras regiones, incluido Estados Unidos: el principio de las 3R para reemplazar, reducir y refinar el uso de animales en la ciencia (Russell y Burch, 1959; Oficina de Bienestar Animal de Laboratorio, 2015). Estos principios se basan no solo en consideraciones éticas para los animales, sino también en consideraciones científicas sobre las limitaciones del uso de animales no humanos para modelar la biología, la salud y las enfermedades humanas.
Las pruebas con animales suelen ser costosas, requieren mucho tiempo y pueden arrojar resultados engañosos (Meigs et al., 2018). Aproximadamente el 92 % de los fármacos en desarrollo no superan los ensayos clínicos en humanos, principalmente debido a fallos en las pruebas de seguridad y eficacia, a pesar de los hallazgos de seguridad y eficacia demostrados en las pruebas preclínicas (Thomas et al., 2021). Un análisis económico reciente estimó que el uso de tecnologías preclínicas más predictivas no animales en lugar de las pruebas con animales podría ahorrar más de 24.000 millones de dólares (Ewart et al., 2022). Existe un creciente reconocimiento entre los científicos gubernamentales, académicos e industriales de que los métodos de investigación sin animales tienen el potencial de superar algunas de las limitaciones científicas de los métodos basados en animales (Baran et al., 2022; Gribaldo y Dura, 2022; Ingber, 2022; Comité Asesor del Director del Grupo de Trabajo sobre la Catalización del Desarrollo y Uso de Nuevos Métodos Alternativos para el Avance de la Investigación Biomédica, 2023).
En los últimos años, los modelos de investigación in vitro (en placa) e in silico (computacionales) se han vuelto cada vez más eficaces y accesibles, reemplazando el uso de animales en diversas aplicaciones y convirtiéndose en una herramienta crucial para la investigación preclínica. Estos nuevos y prometedores modelos utilizan la biología humana, las células y bases de datos para imitar estados fisiológicos humanos complejos y respuestas terapéuticas (Shaker et al., 2021; Loewa et al., 2023). Ejemplos de modelos in vitro innovadores basados en la biología humana son los organoides, los órganos en chip (también llamados chips de órganos y chips de tejido) y las células madre pluripotentes inducidas. Los organoides son agregados celulares tridimensionales (también llamados esferoides) compuestos por múltiples tipos de células y diseñados para imitar procesos fisiológicos. Los sistemas de órganos en un chip humanos son microdispositivos compuestos por células y fluidos tridimensionales que simulan los procesos fisiológicos en los órganos humanos. Las células madre pluripotentes inducidas son células adultas derivadas de humanos que han sido reprogramadas genéticamente a un estado similar al de las células madre y posteriormente modificadas para obtener uno de los diversos tipos celulares presentes en todo el cuerpo.
El uso de animales en la investigación ha sido tan prolongado que la comunidad científica ha tardado en aceptar nuevos métodos no animales. Algunos de estos nuevos métodos tienen un alto coste inicial y pueden resultar difíciles de implementar en los laboratorios de los investigadores, lo que pone de manifiesto la necesidad de mayor financiación y una infraestructura más amplia (Busek et al., 2022). La aceptación de nuevos métodos sin animales también puede mejorarse mediante buenas prácticas de laboratorio que garanticen la realización de experimentos de alta calidad y la reproducción de los hallazgos por parte de otros investigadores, así como mediante una evaluación exhaustiva de los modelos para confirmar la idoneidad de los experimentos para el uso previsto (Pamies et al., 2022; van der Zalm et al., 2022).
Sin embargo, otras barreras para un uso más amplio de métodos sin animales son de carácter más psicológico, como el sesgo o la preferencia por los métodos basados en animales. Este sesgo en los métodos animales puede ser especialmente frecuente cuando se evalúan investigaciones que utilizan métodos sin animales durante evaluaciones subjetivas de estudios para su publicación o propuestas de financiación. Al afectar las publicaciones y las subvenciones, el sesgo en los métodos animales puede constituir un obstáculo para la difusión y la adopción de nuevos enfoques sin animales, lo que dificulta una mejor predictibilidad preclínica y complica aún más el desarrollo de fármacos. A continuación, se amplía el concepto de sesgo de los métodos animales, incluida una descripción general de la evidencia actual, cómo afecta a las evaluaciones de investigación y los esfuerzos en curso para mitigar sus efectos nocivos en la investigación de la salud humana.
Sesgo en los métodos animales: el sesgo hacia la experimentación animal en la investigación y la publicación
La publicación desempeña un papel crucial en el avance científico, ayudando a traducir los hallazgos de la investigación en intervenciones médicas. También impacta a la carrera de los investigadores, influyendo en las decisiones de contratación y otras evaluaciones. Sin embargo, el proceso de publicación no está exento de sesgos. Según el Catálogo de Sesgos, una base de datos de sesgos psicológicos, metodológicos y de publicación creada por el Centro de Medicina Basada en la Evidencia de la Universidad de Oxford, el sesgo de publicación se define como «cuando la probabilidad de que un estudio se publique se ve afectada por sus hallazgos» (DeVito y Goldacre, 2019). Pero ¿qué ocurre si la probabilidad de que un estudio se publique se ve afectada por los métodos del estudio, es decir, métodos con animales o sin animales? En su artículo, ¿Es hora de que el tercer revisor solicite experimentos con chips de órganos humanos en lugar de estudios de validación con animales?, el Dr. Donald Ingber cuestionó porqué los datos animales todavía se consideran el estándar de oro en la investigación de la salud humana, al tiempo que presentó evidencia de que los chips de órganos pueden ser más adecuados para este propósito (Ingber, 2020).
El sesgo de los métodos animales en la investigación es, por tanto, un nuevo tipo de sesgo de publicación, que describe una preferencia por los métodos basados en animales cuando no son necesarios o cuando los métodos sin animales son apropiados, lo que afecta a la probabilidad de que un artículo sea aceptado para su publicación o provoca un retraso significativo en la aceptación del artículo. El sesgo de los métodos con animales también afecta a otros aspectos de investigación, como la revisión de las solicitudes de financiación, cuando los investigadores postulan a fondos para sus proyectos sin animales pero se ven frenados por evaluaciones sesgadas de sus propuestas. Puede compararse con otro tipo de sesgo denominado sesgo académico, que consiste en favorecer las perspectivas, teorías o métodos que coinciden con los propios (Langfeldt et al., 2023).
Para entender mejor cuándo y porqué ocurre esto, lo que a su vez informa las soluciones, el primer autor de este artículo y sus colegas realizaron una pequeña encuesta para evaluar las experiencias y percepciones de los autores y revisores relacionadas con experimentos en biología animal y humana durante la revisión por pares (Krebs et al., 2023b). Los encuestados representaban una amplia gama de la investigación biomédica y campos relacionados, trabajaban principalmente en el sector académico (74%) e industrial (10%), y en los Estados Unidos (32%). 21 de los 68 encuestados indicaron que habían realizado experimentos con animales con el único propósito de anticiparse a las peticiones de los revisores. En otras palabras, ellos no pensaban que los experimentos fueran necesarios fuera del contexto de la revisión, 31 de los 68 encuestados indicaron que los revisores les habían pedido que añadieran experimentos con animales a un estudio que, de otra manera, no los tendría. Entre esos 31 encuestados, sólo tres indicaron que consideraban que la petición estaba justificada, mientras que 14 encuestados consideraban que a veces estaba justificada y 11 no pensaban que la petición estuviera justificada (tres encuestados no respondieron a esta pregunta).
Cuando se les pidió que dieran más detalles sobre su percepción de estas peticiones, los encuestados manifestaron que los revisores piden experimentos con animales por costumbre, no porque sea necesario o pertinente. Algunos encuestados también indicaron que es más probable que las revistas más importantes soliciten o esperen experimentos con animales, lo que actúa como incentivo para la realización de experimentos con animales o como castigo para los investigadores que utilizan métodos sin animales y basados en la biología humana. En general, la encuesta identificó las siguientes consecuencias del sesgo en los métodos con animales durante la revisión de pares: la realización de experimentos con animales que de otro modo no se habrían llevado a cabo, así como repercusiones negativas en la carrera profesional, incluidos retrasos en la publicación, rechazo o retirada de artículos, y verse obligados a publicar en revistas menos prominentes.
La encuesta también incluía preguntas sobre las experiencias de los encuestados como revisores y, en concreto, sobre las razones para solicitar más experimentos con animales. Los encuestados indicaron que su preferencia por los métodos con animales o su desconocimiento de métodos adecuados sin animales eran razones para solicitar más experimentos con animales.
Debido a las presiones para publicar, los investigadores pueden sentirse obligados a acceder a las peticiones de los revisores para realizar experimentos con animales incluso cuando no están de acuerdo con su pertinencia. Por otra parte, el incumplimiento de estas peticiones puede tener consecuencias negativas para su carrera. En conjunto, el sesgo de los métodos con animales afecta a la forma en que se publica la investigación sin animales y puede incluso disuadir a los investigadores de utilizar estos métodos. En otras palabras, es un obstáculo para la adopción y divulgación de la investigación sin animales - una investigación importante que promete mejorar la predicción preclínica y los índices de conversión del descubrimiento de fármacos a la aprobación de ensayos clínicos.
Cómo mitigar el sesgo hacia métodos animales
En abril de 2022 se llevó a cabo un taller para abordar el sesgo hacia métodos con animales en la publicación científica. En él participaron investigadores del ámbito académico e industrial, editores de revistas científicas, representantes gubernamentales y defensores, con el objetivo de: (1) explorar diversas perspectivas de los actores involucrados, (2) describir el estado actual de los sistemas experimentales basados en animales y en métodos alternativos, (3) describir el sesgo hacia métodos con animales en la publicación y otros sesgos relacionados en la revisión por pares, y (4) identificar posibles causas, consecuencias y estrategias de mitigación para este sesgo en la publicación (Krebs et al., 2022).
Se identificaron barreras para abordar este sesgo, entre ellas:
♥ La naturaleza de alta presión del entorno de investigación.
♥ El factor de impacto, un índice que mide el impacto de la literatura académica representando el promedio anual de citas a artículos publicados en cada revista durante los últimos 2 años.
♥ Intereses financieros.
♥ Los animales como el "estándar de oro", vistos como el método por defecto dentro de la comunidad científica.
♥ Inercia institucional y bloqueo psicológico (ver Gluck, 2019).
♥ Falta de conocimiento o interés en aprender sobre métodos libres de animales.
Los asistentes al taller también identificaron recomendaciones para abordar el sesgo hacia métodos con animales dirigidas a la comunidad científica, revistas y editoriales, financiadores, gobiernos y responsables de políticas públicas. Estas recomendaciones incluyen:
♥ Generar conciencia sobre el sesgo hacia métodos con animales entre editores, revisores por pares y la comunidad científica en general, especialmente entre investigadores en etapas tempranas de sus carreras;
♥ Aumentar la confianza de los autores para desafiar las solicitudes de experimentos con animales por parte de los revisores, utilizando herramientas como la Guía para Autores para Abordar el Sesgo hacia Métodos con Animales (Krebs et al., 2023a);
♥ Proporcionar materiales educativos para revisores, como recientemente ha reconocido el Instituto Nacional de Salud (NIH) de EE.UU., para garantizar una mejor evaluación de la investigación sin animales (Advisory Committee to the Director Working Group on Catalyzing the Development and Use of Novel Alternative Methods to Advance Biomedical Research, 2023);
♥ Exigir que cualquier solicitud de inclusión de métodos con animales sea revisada por otros revisores; y
♥ Priorizar el financiamiento para métodos libres de animales basados en biología humana, incluyendo la mejora de su accesibilidad y formación para investigadores.
Después del taller, los asistentes formaron la Coalition to Illuminate and Address Animal Methods Bias (COLAAB) para continuar explorando y abordando esta problemática. Actualmente, COLAAB está recopilando más evidencia sobre el sesgo hacia métodos con animales y sus consecuencias, y desarrollando e implementando herramientas para superarlo.

Está en nuestras manos
Los nuevos métodos no basados en animales tienen un enorme potencial para avanzar en la investigación biomédica y el desarrollo de medicamentos. Aunque aún queda mucho trabajo por hacer para lograr una aceptación plena de estos métodos dentro de la comunidad científica, cada vez más investigadores los utilizan para responder a sus preguntas de investigación. Estos investigadores deberían poder hacerlo sin enfrentar solicitudes o expectativas injustas de realizar experimentos con animales por parte de revisores que prefieren sus propias metodologías o no están capacitados para evaluar métodos innovadores.
El sesgo hacia métodos con animales es un problema serio que impone trabajo adicional e innecesario a quienes utilizan enfoques libres de animales y perpetúa la idea de que estos métodos no son suficientemente valiosos por sí mismos. Este sesgo es un síntoma de un ecosistema de investigación que recompensa el uso de animales y desalienta el cambio hacia métodos basados en biología humana, potencialmente más confiables, constituyendo así una barrera para romper la dependencia del modelo animal. Para avanzar en la investigación biomédica y lograr medicamentos más seguros y efectivos para más pacientes, investigadores, desarrolladores de medicamentos y agencias financiadoras deben abordar el sesgo hacia métodos con animales. Serán esenciales las medidas que empoderen a los investigadores para enfrentar solicitudes injustas, prevengan a los revisores de hacerlas, y promuevan la estandarización, evaluación e infraestructura para enfoques de investigación sin animales.
El público también puede desempeñar un papel fundamental. Los consumidores y contribuyentes tienen poder en el mercado y en la investigación financiada con fondos públicos, y ya están ayudando a impulsar el cambio al exigir cosméticos libres de crueldad y apoyar a legisladores que promueven la investigación y las pruebas sin animales.
Si quieres leer la nota completa haz click aquí.
Esta nota fue traducida por Jamir y Gaby.
Comparte:
Copiar URL Más posts de raquelAl enviar tus consultas o comentarios estás accediendo a recibir nuestro newsletter de forma mensual.
AGREGAR UN COMENTARIO